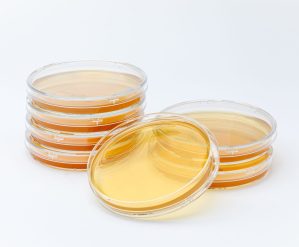
Two rows of stacked TSA plates with one plate in front of the stacks.

Services and Solutions
Eagle offers comprehensive services to CGMP facilities, including those that are sterile or non-sterile. Our solutions are designed to help identify potential risks, challenges, and opportunities, all while remaining grounded in scientific principles. We understand the importance of regulatory compliance, and our expert guidance can help you achieve it in a cost-effective manner. You can trust that your compliance needs are in good hands with our team. Let Eagle’s capabilities, experiences and expertise work for your 503B outsourcing facility.
“Our desire, dedication, and discipline to ensure that patient safety is at the forefront of everything we do and our holistic approach to resolving your compliance needs make Eagle a truly unique organization.”
— President and CEO, Ross A. Caputo, Ph.D.
Consulting Services
Our consulting team is composed of professionals spanning the pharmaceutical industry with expertise in CGMP, QC/QA, Sterile Preparations, Nonsterile Preparations, and Hazardous Drugs. Our experts excel at helping facilities identify challenges, risks, opportunities, and implement cost-effective, science-based solutions. We take a holistic approach to resolving your needs. With Eagle’s guidance, you will feel confident with your compounding safety procedures and adherence to regulations. Learn More
Rapid Sterility Testing | ScanRDI®
ScanRDI® is non-growth-based technology sensitive enough to detect a single bacterial, yeast, or mold contaminant in a matter of hours. Even spores, stressed and fastidious organisms are detected in minutes, offering an extraordinarily rapid alternative to traditional sterility testing. This validated alternative sterility test fulfills the method suitability requirement as outlined in USP <1223>. ScanRDI® has revolutionized the rapid microbial detection of organisms in solutions and soluble products with speed and sensitivity that is unrivaled. Eagle’s ScanRDI® Sterility Test Protocol is an FDA-accepted alternative to the official USP <71> sterility test that can take 14-18 days to complete.
As an industry leader in ScanRDI®sterility testing, Eagle can deliver your test results in as little as 1 business day.

Media-Fill Testing
Media-fill testing should be performed by all sterile compounding facilities to evaluate and/or qualify an operator’s aseptic technique and challenge the aseptic process. The aseptic process is simulated utilizing soybean-casein digest, a liquid media supporting and promoting microbial growth, under worst-case conditions.
Eagle offers the following testing and advisory services to satisfy the USP <797> requirements for media-fill testing:
- Media-fill protocol development
- Incubation and evaluation of media-filled units
- Microbial identification growth in media-filled units
- Post media-fill growth promotion testing
Pricing Request | Testing Services | Microbiological Department Services
Compendia Testing or Component Testing (Bulk Drug Testing)
United States Pharmacopoeia (USP), European Pharmacopoeia (EP), British Pharmacopoeia (BP), and Japanese Pharmacopoeia (JP) compendial testing qualifies drug substances and excipients as well as drug products to meet pharmacopoeia specifications.
Compendial testing of raw materials is a critical component of a supplier/ vendor qualification program. Testing consists of procedures and acceptance criteria that help ensure the identity, strength, quality, and purity of the article. Pricing Request
Smoke Studies
Smoke studies are a key qualification to ensure that your products are free from contamination and that your staff is operating in a safe environment.
Eagle’s smoke studies include a Static Air Visualization study and a Dynamic Air Visualization study with video and report. With Eagle’s engineers performing your smoke study, you and your staff will feel confident that your equipment is operating. Learn More

Stability Studies
According to the United States Food and Drug Administration (FDA) and the International Conference on Harmonization of Technical Requirements for Registration of Pharmaceuticals for Human Use (ICH), the purpose of stability testing is to provide evidence on how the quality of a drug substance or drug product varies with time under the influence of a variety of environmental factors such as temperature, humidity, and light, and to establish a re-test period for the drug substance or a shelf life for the drug product and recommended storage conditions.
Stability studies for sterile products generally include:
- Appearance (Color, clarity, order)
- Antimicrobial effectiveness testing
- Assy/Potency measurement using stability indication validated analytical method(s)
- Container-closure integrity testing
- Endotoxin testing
- Impurities testing
- Particulate matter
- pH
- Sterility Testing
Stability studies for non-sterile products generally include:
- Appearance (Color, clarity, order)
- Antimicrobial effectiveness testing
- Assy/Potency measurement using stability indication validated analytical method(s)
- Bioburden testing
- Impurities testing
- Particulate matter
- pH
- USP <51> Antimicrobial effectiveness testing
- USP <60> Testing for Burkholderia cepacia
- USP <61> Microbial enumeration testing
- USP <62> Objectionable microorganism testing
Sources:
- FDA (November 2023). Q1A(R2) Stability Testing of New Drug Substances and Products. Retrieved from https://www.fda.gov/regulatory-information/search-fda-guidance-documents/q1ar2-stability-testing-new-drug-substances-and-products.
- FDA (November 2003). [PDF] ICH. Guidance for Industry. Q1A(R2) Stability Testing of New Drug Substances and Products. Retrieved from https://www.fda.gov/media/71707/download
Pricing Request | Testing Services | Stability Study Questionnaire
USP <51> Antimicrobial Effectiveness Testing
Antimicrobial effectiveness, whether inherent in the product or as a result of an antimicrobial preservative, must be demonstrated through USP <51> antimicrobial effectiveness testing. Sterile articles packaged in multi-dose containers must be free of microorganisms throughout their entire shelf life. Due to the potential for the introduction of microorganisms through the repeated withdrawal of individual doses, sterile products that are packaged in multi-dose containers should contain an antimicrobial preservative. However, the concentration of an added antimicrobial preservative can be kept to a minimum if the ingredients of the compounded formulation possess an intrinsic antimicrobial activity. Microbiological Department

USP <85> Bacterial Endotoxins Testing
As bacterial endotoxins can pose health and safety hazards to patients, USP <85> requires bacterial endotoxin testing to detect and quantify the presence of endotoxins from Gram-negative bacteria in sterile compounds.
To ensure patient safety, the quantity of bacterial endotoxins may not exceed threshold limits defined in USP <85>. For each bacterial endotoxin test, inhibition validation testing is performed. This testing confirms that there are no components of the formulation that will interfere with the bacterial endotoxin test and that the testing used is sensitive enough to provide meaningful, accurate data. Pricing Request
Related Resource:
Cleanroom Certification
To ensure your cleanroom is operating properly, a full cleanroom inspection is conducted. This inspection includes HEPA Filter Integrity Testing, Differential Pressure Measurement, Air Change Per Hour Measurement and Calculation, and more.
Eagle knows that you rely on your equipment to perform as expected and that your cleanroom is designed to operate as a safeguard for the quality of your products and for the well-being of your staff. With us, you will feel confident that your equipment and cleanroom are operating as intended. Learn More

Environmental Monitoring Services
Environmental monitoring (EM) is a key element in ensuring that aseptic processing areas are maintained in an adequate state of control. With recent USP published revisions going into effect this year and potential contamination always being a concern, it is important to meticulously test your compounding environment to ensure there are no unknown contaminants, which can affect the safety of your patients and ultimately the integrity of your business.
 Our 65 mm TSA (tryptic soy agar), with Lecithin and Tween 80, contact plates supplemented with neutralizers are ideal for environmental monitoring; recovering a wide array of microorganisms from surfaces, personnel, and active air samples. Growth promotion testing included. Related services, i.e. Incubation and Enumeration of Media, Microbial Identification, Temperature Mapping, and more are offered.
Our 65 mm TSA (tryptic soy agar), with Lecithin and Tween 80, contact plates supplemented with neutralizers are ideal for environmental monitoring; recovering a wide array of microorganisms from surfaces, personnel, and active air samples. Growth promotion testing included. Related services, i.e. Incubation and Enumeration of Media, Microbial Identification, Temperature Mapping, and more are offered.
Our 90 mm TSA (tryptic soy agar), with Lecithin and Tween 80, contact plates supplemented with neutralizers are ideal for environmental monitoring; recovering a wide array of microorganisms from surfaces, personnel, and active air samples. Growth promotion testing included. Related services, i.e. Incubation and Enumeration of Media, Microbial Identification, Temperature Mapping, and more are offered.
Our 90 mm TSA (tryptic soy agar), with Lecithin and Tween 80, contact plates supplemented with neutralizers are ideal for environmental monitoring; recovering a wide array of microorganisms from surfaces, personnel, and active air samples. Growth promotion testing included. Related services, i.e. Incubation and Enumeration of Media, Microbial Identification, Temperature Mapping, and more are offered.
This test identifies microorganisms isolated during different phases of manufacturing and quality testing to the genus/species level using DNA sequencing. Microbial Identification is also critical in a Sterility Out-of-Specification investigation, and useful information during Bioburden testing.
Microbiological Department | Pricing Request | Eagle Testing Services
This new feature found in Eagle’s EagleTrax app named Shield Analysis provides a comprehensive and retrospective review of personnel and EM data as well as critical quality attributes of the compounded preparation, enabling users to analyze trends over time. Note that access to Eagle Trax requires registration as a client. Eagle offers various types of reports, including Microbial Identification, Potency Average, Potency Multiple Analytes, Potency Trends, SCANRDI®, USP <71> Sterility, and USP <85> Bacterial Endotoxin and USP <800> Hazardous Drugs reporting.
For assistance with EagleTrax registration, please contact Client Care.
The USP <61> Microbial Examination of Nonsterile Products: Microbial Enumeration Tests provide a quantitative evaluation of a product’s microbial content to demonstrate compliance with established specifications.
As the presence of microorganisms in nonsterile preparations has the potential to reduce and/or inactivate therapeutic activity and adversely affect the health of patients, compounders are required to ensure that nonsterile preparations have a low bioburden that complies with established specifications for microbiological quality as outlined in USP <61>.
Microbiological Department | Pricing Request | Eagle Testing Services
The USP <62> Microbiological Examination of Nonsterile Products: Tests for Specified Microorganisms are designed to demonstrate compliance with these requirements by quantifying the presence of specified microorganisms.
Table 1 in USP <1111> sets acceptance criteria for the presence of certain microorganisms in a nonsterile preparation based on its route of administration. The presence of these objectionable pathogens and microorganisms cannot exceed the acceptance criteria outlined in Table 1.
Microbiological Department | Pricing Request | Eagle Testing Services
Potency Testing
Potency testing measures the concentration of the active pharmaceutical ingredient (API) at a specific point in time. Eagle uses advanced HPLC/UHPLC and Spectrographic instrumentation and protocols developed based on USP <621> and <851> methodology. Testing Services
Finished Drug Product Release Testing

USP <60> Burkholderia Cepacia Complex (Bcc)
Determining the presence of Bcc is vital, especially for inhalation use or aqueous preparations for oral, oromucosal, cutaneous, or nasal use. A USP <60> Burkholderia Cepacia Complex test determines whether a substance or preparation complies with an established specification for microbiological quality.
USP <71> Method Suitability Testing
USP <71> Method Suitability Testing (MST) must be performed prior to being able to claim that the results of a USP <71> sterility test provide evidence of a preparation’s sterility.
USP <71> Sterility Tests
A sterility test detects microbial contamination. A satisfactory result indicates that no contaminating microorganism has been found in the sample examined under the conditions of the test. Method suitability is performed to ensure contamination can be detected under the conditions of the test, providing confidence in the test result.
USP <71> outlines the compendial requirements for sterility testing that must be followed in order to be able to claim that the results of the test provide evidence that the product is sterile. Testing Services
USP <788> & USP <789> — Particulate Matter
Solutions must be essentially free from observable particulate matter. Due to the small amount of material and the heterogenous composition that particulate matter represents, it cannot be quantitated by chemical analysis alone. Particulate Matter testing is performed on all parenteral solutions to determine the cleanliness and stability of the solution.
USP <788> Particle Matter In Injections
The USP (United States Pharmacopeial) General Chapter <788> states, “Particulate matter in injections and parenteral infusions consists of extraneous mobile undissolved particles, other than gas bubbles, unintentionally present in the solutions.” There are two procedures that may be used to determine the particulate matter:
Method 1: Light Obscuration Particle Count Test
This method is preferred when examining injections and parenteral infusions for subvisible particles. Method 1 is broken down into Test 1.A and Test 1.B. Please see the USP <788> reference for details.
Method 2: Microscopic Particle Count Test
When Method 1 is not applicable, e.g., in the case of preparations having reduced clarity or increased viscosity, the test should be carried out according to Method 2. Method 2 uses a suitable binocular microscope, a filter assembly for retaining particulate matter, and a membrane filter for examination.
USP <789> Particle Matter in Ophthalmic Solutions
USP <788> states, “Particulate matter consists of mobile, randomly sourced, extraneous substances, other than gas bubbles, that cannot be quantitated by chemical analysis because of the small amount of material they represent and because of their heterogeneous composition. Ophthalmic solutions should be essentially free from particles that can be observed on visual inspection. The tests described herein are physical tests performed for the purpose of enumerating extraneous particles within specific size ranges.”
Microbiological Department | Pricing Request | Eagle Testing Services
- USPNF.com (2023). USP <788> Particle Matters In Injections. Revision Bulletin, July 1, 2012. Retrieved from https://www.uspnf.com/sites/default/files/usp_pdf/EN/USPNF/revisions/788_particulate_matter_in_injections.pdf.
- USPNF.com (2023). UPS <789> Particle Matter in Ophthalmic Solution. Retrieved from https://doi.usp.org/USPNF/USPNF_M99587_01_01.html.
USP <1207> Container-Closure Integrity Testing
USP <1207> container-closure integrity testing demonstrates the ability of the container-closure system to maintain the integrity of its microbial barrier throughout the entire shelf-life of a product.

Download this handy reference guide to learn how Eagle can assist your 503B facility in meeting your various regulatory requirements.

Get Started Today
Need Assistance?
Call the Eagle Client Care Team at (800) 745-8916 to discuss your operation’s specific needs and answer any questions!
